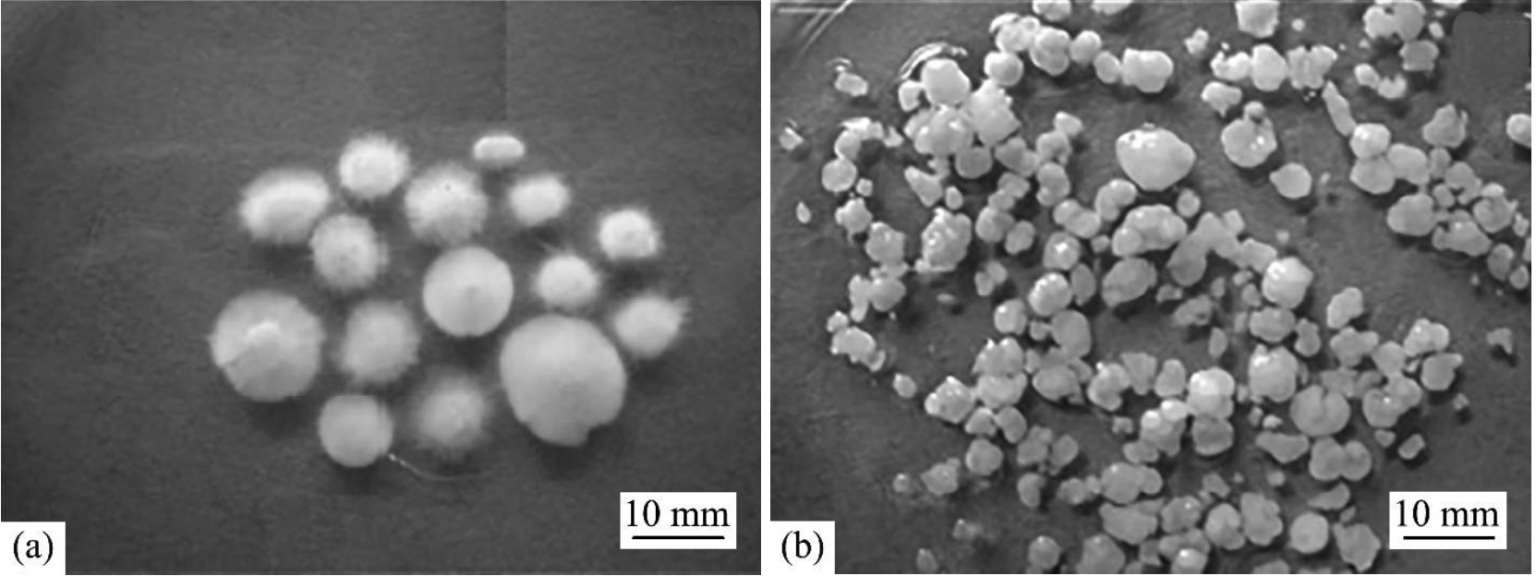

众多参数会影响好氧颗粒污泥的形成过程,比如接种污泥、基质组成、有机负荷(organic loading rate,OLR)、进食策略、反应器构型、沉降时间(settling time,ST)、体积交换律和曝气强度(体现水力剪切力)等。
活性污泥系统中较多的微生物群落对好氧颗粒污泥的形成过程具有重要影响,因此大部分研究选取活性污泥作为培养好氧颗粒污泥的接种污泥 [2] 。不同菌体具有不同的物理化学特性,导致其表现出不同的凝聚能力 [28] 。相对于亲水性细菌而言,疏水性细菌更易黏附在污泥絮体上 [29] 。接种污泥中疏水性微生物越多,越容易快速地形成沉降性能好的颗粒污泥 [30] 。
适于培养好氧颗粒污泥的基质种类众多,包括乙酸、葡萄糖、苯酚、乙醇、淀粉、蔗糖、糖浆和合成污水
[31-35]
,也有研究者利用实际污水培养好氧颗粒污泥
[36-39]
。研究显示碳源会显著影响颗粒的种群结构
[19]
,以苯酚作为碳源和能源物质培养好氧颗粒污泥,优势种群为
Proteobacterium
[35,40]
。以无机碳源和氨氮
 作为培养基质,好氧颗粒污泥中优势种群为亚硝化菌(ammonia oxidizing bacteria,SOB)和硝化菌(nitrite oxidizing bacteria,NOB)
[41,42]
。以葡萄糖和乙酸作为碳源、硝氮
作为培养基质,好氧颗粒污泥中优势种群为亚硝化菌(ammonia oxidizing bacteria,SOB)和硝化菌(nitrite oxidizing bacteria,NOB)
[41,42]
。以葡萄糖和乙酸作为碳源、硝氮
 作为氮源,好氧颗粒污泥中优势种群为
Epistylis
、
Poterioochromonas
、
Geotrichum
和
Geotrichum klebahnii
[43]
。Xiang等
[44]
以高负荷苯胺作为单一碳源和氮源培养好氧颗粒污泥,在颗粒中分离出两株纯菌,分别是
Pesudomonas
sp.adx1和
Achromobacter
sp.adx3,它们对苯胺的降解效果分别达到0.924 g/(g·h)和0.645 g/(g·h)。
作为氮源,好氧颗粒污泥中优势种群为
Epistylis
、
Poterioochromonas
、
Geotrichum
和
Geotrichum klebahnii
[43]
。Xiang等
[44]
以高负荷苯胺作为单一碳源和氮源培养好氧颗粒污泥,在颗粒中分离出两株纯菌,分别是
Pesudomonas
sp.adx1和
Achromobacter
sp.adx3,它们对苯胺的降解效果分别达到0.924 g/(g·h)和0.645 g/(g·h)。
OLR会显著影响好氧颗粒污泥的形成速度和颗粒中种群结构 [45] 。在OLR较低的条件下[1.5 Kg COD/(m 3 ·d)],好氧颗粒污泥的形成速度较慢,粒径小,结构紧实,且微生物多样性高。较高的OLR[4.5 Kg COD/(m 3 ·d)]会加速好氧颗粒污泥的形成过程,但是,好氧颗粒污泥粒径大、结构疏松。Li等 [46,47] 研究证实,好氧颗粒污泥中生物多样性会随OLR增加而降低。可见,好氧颗粒污泥的形态和动力学特性均受OLR影响。然而目前的研究表明,OLR在2.5~15 Kg COD/(m 3 ·d)范围内均可以培养出好氧颗粒污泥 [48,49] ,可见好氧颗粒污泥的形成并不单纯取决于OLR。
Yang等
[50]
研究N/COD(5/100~30/100)对好氧颗粒污泥形成过程的影响,结果发现只有在游离氨(free ammonia,FS)浓度低于23.5 mg/L的环境下才能培养出好氧颗粒污泥(图1.6),这是因为高于此阈值时,FS会显著降低细胞疏水性,并影响EPS产量,继而阻碍好氧颗粒污泥的形成过程。但是,当处理无机污水时,FS对颗粒化过程的影响并不显著。Shi等
[51]
以高负荷
 无机污水为进水,经过120天培养出了平均粒径为0.32 mm的自养硝化好氧颗粒污泥。Chen等
[52]
通过迅速提高
无机污水为进水,经过120天培养出了平均粒径为0.32 mm的自养硝化好氧颗粒污泥。Chen等
[52]
通过迅速提高
 负荷(由200 mg/L增至1000 mg/L)结合短ST运行模式,经过55天培养出自养硝化好氧颗粒污泥。
负荷(由200 mg/L增至1000 mg/L)结合短ST运行模式,经过55天培养出自养硝化好氧颗粒污泥。



图1.6 不同N/COD条件下培养的污泥形态 [50]
(a)N/COD为5/100的反应器中的颗粒污泥;(b)N/COD为10/100的反应器中的颗粒污泥;(c)N/COD为15/100的反应器中的颗粒污泥;(d)N/COD为20/100的反应器中的污泥;(d)N/COD为30/100的反应器中的污泥
ST和体积交换率的设定是为了筛选并淘洗掉非颗粒状絮体。较短的ST可以将沉降速率差的悬浮污泥淘洗出反应器,截留沉降性好的好氧颗粒污泥 [13,53] 。研究证实短ST可强化好氧颗粒污泥的形成过程 [49,54,55] 。细胞的表观特性会随ST的延长或缩短发生相应的变化,然而其机理并不明确。Sdav等 [56] 考察ST分别为5 min、7 min和10 min对好氧颗粒污泥形成过程的影响,结果显示ST会引起微生物群落的变化(图1.7),短ST会较早地淘洗出非絮凝菌株,避免其与絮凝性菌株竞争。但是在反应器内富集絮凝性菌株,会降低好氧颗粒污泥的生物多样性。

图1.7 ST分别为10min(R1)、7min(R2)和5min(R3)的反应器中样品的溴化乙锭染色图像 [56]
周期时长会影响好氧颗粒污泥的形成过程。Liu等 [57] 研究发现周期时长从1.5h延长至8h,生物量的比生长速率从0.266/d降低至0.031/d,微生物产率从0.316 g/g COD降低至0.063 g/g COD。周期时长为1.5h的条件下,好氧颗粒污泥的粒径最大,而周期时长为4h的条件下,好氧颗粒污泥的结构最为紧实。另外,较短的周期时长可以提高反应器的处理效率,但是对好氧颗粒污泥的稳定性存在不利影响(图1.8)。
曝气机制同样会影响好氧颗粒污泥的形成过程。SBR内曝气过程包括基质降解期(饱食期)和饥饿期两个阶段,这种交替性的饱食_饥饿环境会促使细菌向疏水性转变,继而加速微生物聚集过程 [19,31,58] 。Li等 [14] 指出饥饿环境可将EPS控制在合理的范围,而适宜浓度的EPS是颗粒形成和保持稳定的必要条件。目前关于交替性的饱食饥饿环境对好氧颗粒污泥形成过程的影响机理并不是十分明确。McSwain等 [59] 证实间歇式进食模式可抑制丝状菌繁殖,有利于提高好氧颗粒污泥的紧实度和稳定性。另外,曝气速率的大小对应水力剪切力的强弱,提高曝气速率可相应地强化水力剪切力。Liu等 [20] 和Tay等 [60] 强调水力剪切力有助于培养出结构紧实的好氧颗粒污泥,因为强水力剪切力会产生以下效果:①对颗粒表面进行剥蚀,促进形成表面光滑的好氧颗粒污泥;②刺激微生物分泌EPS,强化好氧颗粒污泥的结构完整度;③降低基质传送阻力,并为微生物降解污染物提供充足的O 2 。但是仅提供高剪切力不一定可以实现污泥的颗粒化过程 [2] 。例如DuleKgurgen等 [61] 通过增大搅拌速度提高水力剪切力,未能将污泥驯化成颗粒污泥。可见,虽然较高的剪切力可以强化颗粒结构,剥离多余细胞等物质,但是好氧颗粒污泥的形成是一个复杂的过程,不是某个单一参数决定的。

图1.8 周期时长分别为1.5h(R1)、4h(R2)和8h(R3)培养的好氧颗粒污泥图 [57]
研究指出,在溶解氧(dissolved oxygen,DO)低至0.7~1 mg/L [9] 或高至2~6mg/L [13,41,62] 条件下,污泥均能实现颗粒化过程,说明DO不同于水力剪切力,不是好氧颗粒污泥形成过程的决定性因素。然而,DO会显著影响好氧颗粒污泥对氮和磷的去除效果 [63] 。研究证实,高强度DO有利于促进硝化反应,但是会限制反硝化过程,相对而言,低强度DO可以强化反硝化过程 [10,64,65] 。
反应器内污泥混合液的pH值会显著影响微生物的生长繁殖。OLR的生化降解过程会产生CO
2
,当溶液不具备缓冲能力或者缓冲能力较弱时,pH值则会下降
[66]
。有研究表明,低pH值适于真菌的生长繁殖,真菌可释放质子并置换溶液中
 ,继而诱发好氧颗粒污泥的最初形成过程
[8,43,66]
。在离子交换过程,溶液pH值会再次降低。报道称,在pH值为4的环境下,好氧颗粒污泥中优势群体为真菌,粒径可达到7 mm,而在pH值为8的环境下,好氧颗粒污泥的优势群体是细菌,粒径相对较小(4.8mm),如图1.9和图1.10所示
[67]
。
,继而诱发好氧颗粒污泥的最初形成过程
[8,43,66]
。在离子交换过程,溶液pH值会再次降低。报道称,在pH值为4的环境下,好氧颗粒污泥中优势群体为真菌,粒径可达到7 mm,而在pH值为8的环境下,好氧颗粒污泥的优势群体是细菌,粒径相对较小(4.8mm),如图1.9和图1.10所示
[67]
。
图1.9 培养70天后的以真菌为主和以细菌为主的好氧颗粒污泥照片 [67]
(a)未添加NaHCO 3 的反应器;(b)添加NaHCO 3 的反应器

图1.10 培养70天后的以真菌为主和以细菌为主的好氧颗粒污泥SEM图 [67]
(a)未添加NaHCO 3 的反应器R1;(b)添加NaHCO 3 的反应器R2
微生物的生长繁殖及大部分代谢过程均会受到温度的影响。目前,培养好氧颗粒污泥的研究大多集中在室温范围内(20~25℃)。在低温下(8℃)培养的好氧颗粒污泥结构不规则,丝状菌会在颗粒上大量繁殖,导致污泥沉降性变差后被淘洗出反应器,最终致使系统失稳 [3] 。